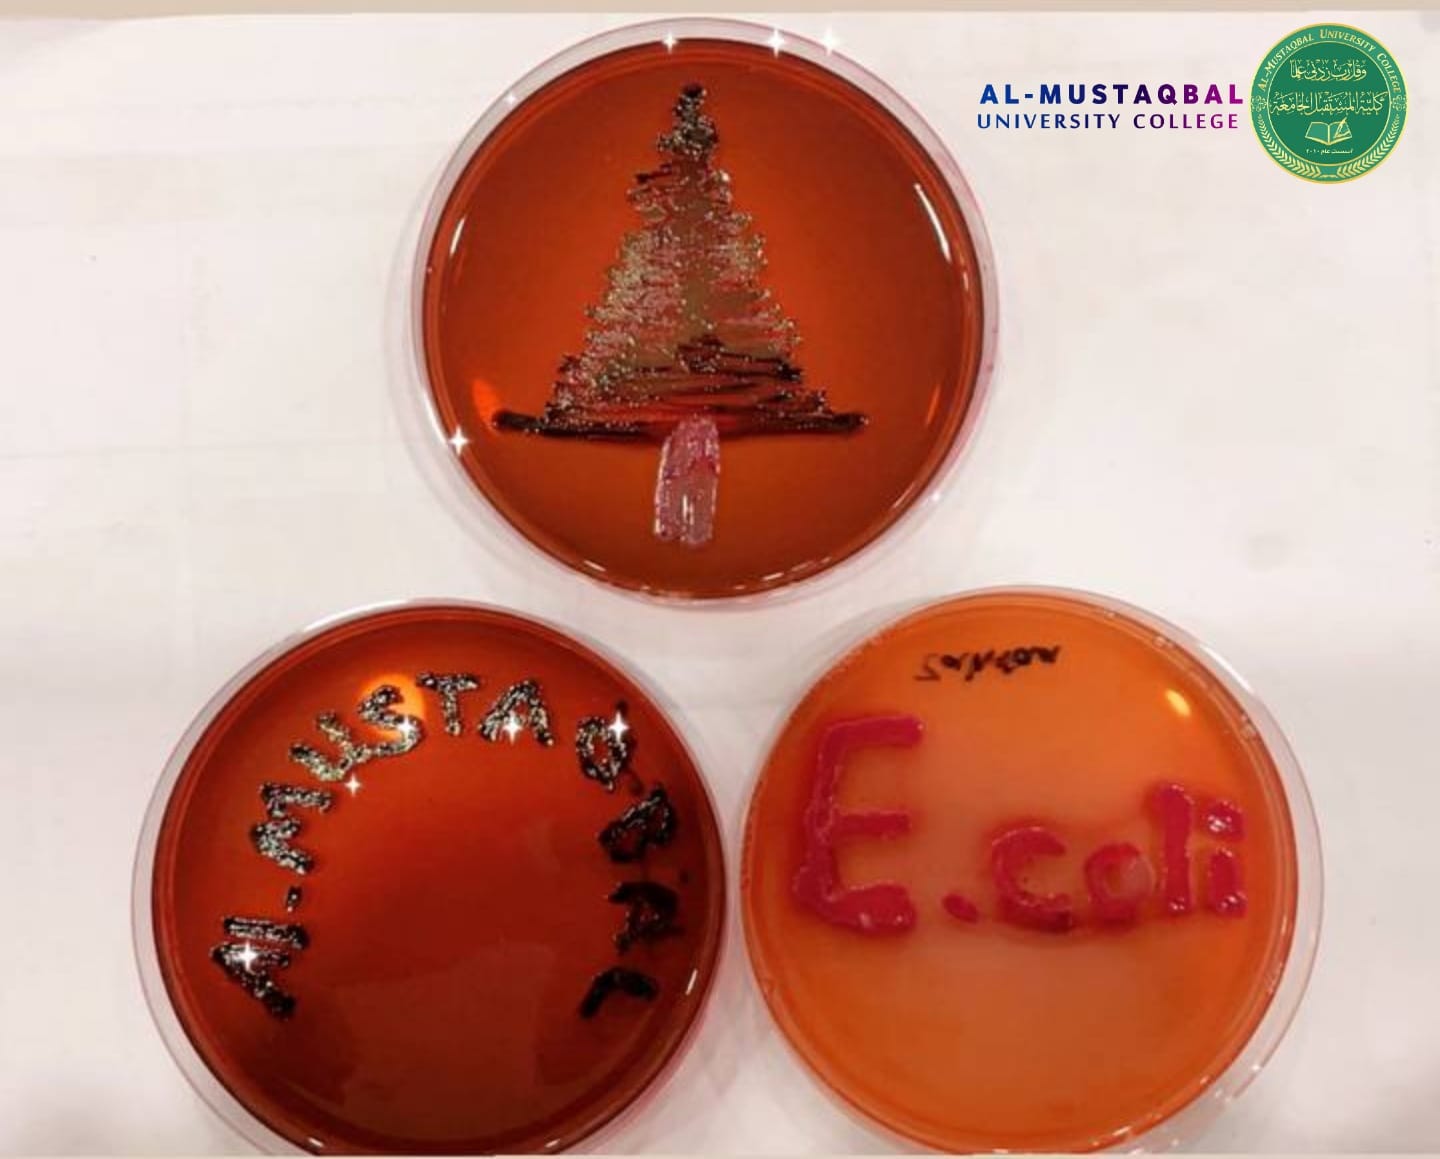
default image

بحوث تخرج طلبة قسم تقنيات المختبرات الطبية ضمن اهداف التنمية المستدامة
344
استمرار عمل بحوث تخرج طلبة المرحلة الرابعة لقسم تقنيات المختبرات الطبية ضمن تحقيق اهداف التنمية المستدامة الهدف الثالث ( الصحة الجيدة والرفاه) حيث تضمن عزل وتشخيص البكتريا الممرضة والملوثة لمنتجات الحليب وقد تم عمل البحث في مختبر البكتريا التشخيصية لقسم تقنيات المختبرات الطبية بأشراف الست م.م زهراء عبد المهدي مجباس . <br />#كليه_المستقبل_الجامعة_نحو_جامعة_مستدامة